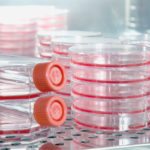
MSc Biology & Life Sciences Job Openings @ IISER Pune

Home Search
cancer - search results
If you're not happy with the results, please do another search
EU’s €34M Project, LITMUS Signs On Integrated BioBank of Luxembourg for Sample Storage
LITMUS Signs On Integrated BioBank of Luxembourg for Sample Storage
A pioneering European research project aims to lead to new diagnostic tests to assess patients...
Biotecnika Times – Newsletter 24.11.2017
Top 10 Biotech Scholarship 2017-18 Every Bio Candidate Must Apply For !
We are here with another Top 10 list of Biotech scholarships 2017-18 which...
Cue Biopharma Reels In $374M through Merck R&D Pact
Cue Biopharma Reels In $374M through Merck R&D Pact
Giant, Merck — which has an R&D team that is built to progress its PD-1 drug Keytruda — has now...
DVD Optics to Map CRISPR/Cas9-Labeled DNA- Latest News
DVD Optics to Map CRISPR/Cas9-Labeled DNA- Latest News
Progress in whole-genome sequencing using short-read (e.g., <150 bp), next-generation sequencing technologies has reinvigorated interest in high-resolution...
Gautam Buddha University Recruitment 2017 – Biological Sciences Candidates Apply
Gautam Buddha University Recruitment 2017 - Biological Sciences Candidates Apply
This job expires in :
A walk-in-interview for a position of a JRF in the ICMR...
Aridis Pharmaceuticals Aims to Use Human Antibodies to Tackle Resistance
Pharmaceuticals Aims to Use Human Antibodies to Tackle Resistance
classes of antibiotics kill bacteria in different ways. Some destroy the cell wall while others interfere...
New Computational Drug-Repositioning Approach Helps Repurpose Old Drugs
New Computational Drug-Repositioning Approach Helps Repurpose Old Drugs
Traditional drug development is expensive and time-consuming, taking an average of 14 years and costing >$2 billion...
Evelo Biosciences, Mayo Clinic Unite to Move Monoclonal Microbials into R&D
Mayo Clinic Unite to Move Monoclonal Microbials into R&D
Evelo Biosciences, a biotech developing therapies with specialized gut microbes is now licensing research from the Mayo...
Researchers Develop Revolutionary Bioprocess Technique that Allows Continuous Production and Collection of Cells
Revolutionary Bioprocess Technique, Allows Continuous Production of Cells
Cell culture is a process where the cells are taken from an animal or plant and grown artificially under controlled...
Scientists “Trim-Away” Proteins to Analyse Its True Function
Scientists “Trim-Away” Proteins to Analyse Its True Function
All the cells in our body contain thousands of proteins, molecular machines which carry out almost all...
Quantum Dots to Mark Tumours
Researchers Found Quantum Dots to Mark Tumours
A simple way to harness the incredible brightness of quantum dots and realize highly sensitive molecular imaging...
Cianna Medical’s Savi Scout Tumor Locator Approved by the FDA
Cianna Medical’s Savi Scout Tumor Locator Approved by the FDA
The FDA has now cleared the world’s first non-radioactive breast tumor localization system for the...
More Efficient Editing with Non-Viral CRISPR-Carrying Nanoparticles
More Efficient Editing with Non-Viral CRISPR-Carrying Nanoparticles
Using a technique known as “nucleic acid origami,” chemical engineers have built tiny particles made out of DNA...
Biotecnika Times – Newsletter 20.11.2017
AcSIR – Dr. APJ Abdul Kalam Summer Training Program 2018 | 20 Fellowships Available
Summer Training Program at AcSIR provides an opportunity to spend one...
PhD Admission 2018 – Spring Semester @ Tezpur University
PhD Admission 2018 - Spring Semester @ Tezpur University
This call ends in :
Online applications are invited from the eligible candidates having valid UGC/CSIR JRF...